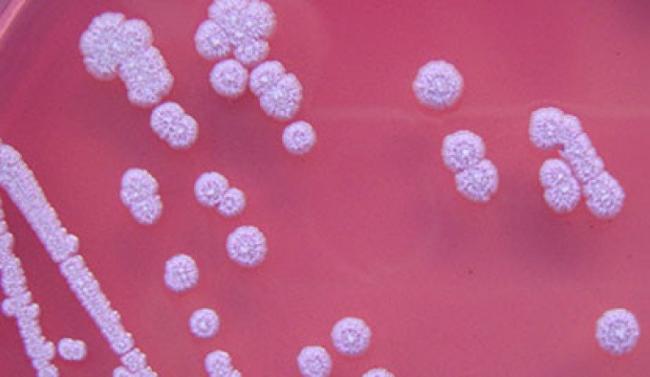

Сап
Обновлено и проверено 03.05.26
Носителями заболевания выступают копытные животные. Проявляется патология инфекционными, эрозивными поражениями кожных покровов, внутренних мягких тканей. В тяжелом течении болезни поражаются оболочки органов, слизистые покровы.
Что такое сап: причины заболевания
Патология переносится на человеческий организм крайне редко, но такие случаи имеют место. Связано это с постоянным контактом с заболевшей особью. Инфекция проникает в человеческое тело через мелкие ранки на коже, через попадание вируса на слизистую. Причинами такого перехода выступают:
- пренебрежение гигиеническими нормами;
- повреждения кожных покровов;
- низкий уровень иммунной защиты организма.
Симптоматика патологии

- резкое и сильное повышение температуры тела, которая сохраняется длительный период;
- в месте проникновения патогена кожа сильно краснеет, образуется язва, покрывается твердой бляшкой (симптом сохраняется в течение недели);
- после двадцати дней течения патологии наступают сильные осложнения на внутренние органы, что приводит к смертельному исходу.
Важно пройти прямую и дифференциальную диагностику. Кроме лабораторных анализов, назначают МРТ головного мозга, чтобы исключить инфекционный менингит.
Если аномалия перетекает в хроническое состояние, то на протяжении многих лет периодически проявляются такие симптомы:
- отечность лицевой части;
- головные боли;
- болезненность в костных тканях, суставах конечностей;
- периодически беспокоят красные высыпания;
- папулы нагнаивается, зудят, нарывают;
- в некоторых случаях появляется течение из носа, выделения имеют сильный неприятный запах.
Как бороться с сапом
Лечение патологии необходимо проводить в обязательном, систематическом порядке. Острая форма нередко заканчивается смертью пациента. Хроническая форма также имеет неблагоприятный финал, так как почти половина заболевших заканчивают жизнь летальным исходом. Если своевременно начать восстановительные мероприятия, прогноз выздоровления имеет хороший процент.
В качестве лечебных мер применяется:
- сульфатиазол-терапия;
- прием витаминных комплексов;
- применение антиоксидантных средств;
- переливание крови;
- установка дренажей на пораженные участки;
- длительный прием антибактериальных веществ;
- введение специальной вакцины.
Людям, имеющим постоянный контакт с животными, рекомендуется применять средства индивидуальной защиты (очки, перчатки), проводить прием периодического профилактического курса сульфатиазола. Лечить заболевших лучше в изолированных инфекционных учреждениях, это предотвратит распространение инфекции.
FAQ
Может ли сап передаваться от человека к человеку?
Случаи передачи сапа от человека к человеку крайне редки, но теоретически возможны при тесном контакте с выделениями больного (гной, носовое отделяемое) через поврежденную кожу или слизистые. Основной резервуар инфекции — больные животные (лошади, ослы, мулы). Люди являются случайным звеном в цепи передачи. При выявлении больного человека он подлежит строгой изоляции в инфекционном стационаре, а все контактные лица — медицинскому наблюдению с ежедневной термометрией и осмотром в течение 14 дней.
Как отличить сап от других язвенных поражений кожи (сибирская язва, туляремия)?
Для сапа характерно образование папул, которые быстро превращаются в пустулы, затем в глубокие язвы с подрытыми краями, гнойным отделяемым и регионарным лимфаденитом. При сибирской язве язва имеет черный струп, безболезненна, с выраженным отеком окружающих тканей. При туляремии первичный аффект часто представлен язвой, но сопровождается резким увеличением регионарных лимфоузлов (бубон), лихорадкой. Окончательная дифференциация проводится бактериологически (посев отделяемого, ПЦР) и серологически (реакция агглютинации, РСК).
Почему сап считается особо опасной инфекцией?
Сап отнесен к группе особо опасных инфекций (ООИ) из-за высокой летальности (до 50–100% при генерализованных формах), отсутствия специфической профилактики (вакцины) и сложности лечения. При выявлении сапа у человека или животного вводятся строгие карантинные мероприятия: изоляция больного, обсервация контактных, дезинфекция очага, уничтожение больных животных, запрет на вывоз и ввоз животных из неблагополучных зон. Информация об инфекции передается в вышестоящие органы здравоохранения по экстренному извещению.
Как долго сохраняется возбудитель сапа во внешней среде?
Возбудитель сапа (Burkholderia mallei) относительно устойчив во внешней среде: в воде и почве сохраняется до 30–40 дней, в трупах животных — до 2–3 месяцев, в зараженных продуктах (молоко, мясо) — до 10–20 дней. Однако бактерия чувствительна к нагреванию (погибает при 55°C за 10–15 минут), действию дезинфицирующих средств (3% раствор хлорамина, 1% раствор формалина, 10% раствор хлорной извести убивают возбудителя в течение 15–30 минут). Для профилактики важна термическая обработка продуктов и тщательная дезинфекция при работе с животными.
Литература
- Vyshelessky S.N. Sap. In: Kurs infektsionnykh bolezney. Vol. 1. Moscow, 1938:412–418.
- Melnikova L.A. Sap: osobo opasnoe infektsionnoe zabolevanie, ego kharakteristika, epizootologiya i diagnostika. Veterinarnyy vrach, 2016;(4):22–26.
- Van Zandt K.E., Greer M.T., Gelhaus H.C. Glanders: an overview of the disease. Journal of Special Operations Medicine, 2013;13(3):86–90. DOI: 10.55460/QD4D-5NTS.
- Wittig M.B., Wohlsein P., Hagen R.M., et al. Glanders: a review of the literature. Clinical Microbiology Reviews, 2019;32(2):e00079-18. DOI: 10.1128/CMR.00079-18.
- Khan I., Wieler L.H., Melzer F., et al. Glanders in animals: a review of the literature. Transboundary and Emerging Diseases, 2011;58(5):405–416. DOI: 10.1111/j.1865-1682.2011.01228.x.
- World Health Organization (WHO). Glanders. In: International Health Regulations. Geneva: WHO Press, 2020.

на МРТ/КТ* в Санкт-Петербурге

